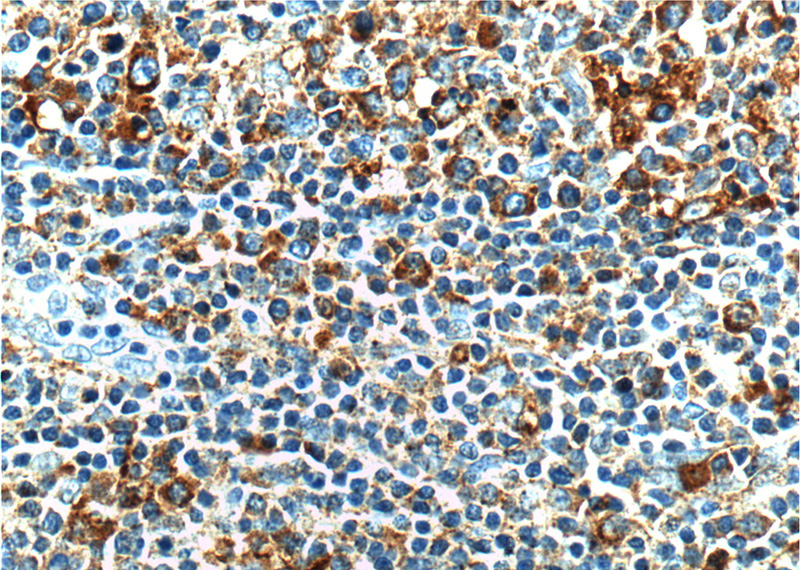
Immunohistochemistry of paraffin-embedded human tonsillitis tissue slide using Catalog No:108415(BAK Antibody) at dilution of 1:200 (under 40x lens).

-
Product Name
BAK antibody
- Documents
-
Description
BAK Rabbit Polyclonal antibody. Positive WB detected in Jurkat cells, A431 cells, RAW 264.7 cells. Positive IF detected in HeLa cells. Positive IHC detected in human tonsillitis tissue, human lymphoma tissue. Observed molecular weight by Western-blot: 28 kDa
-
Tested applications
ELISA, WB, IF, IHC
-
Species reactivity
Human, Mouse; other species not tested.
-
Alternative names
Apoptosis regulator BAK antibody; BAK antibody; BAK LIKE antibody; BAK1 antibody; CDN1 antibody
-
Isotype
Rabbit IgG
-
Preparation
This antibody was obtained by immunization of BAK recombinant protein (Accession Number: NM_001188). Purification method: Antigen affinity purified.
-
Clonality
Polyclonal
-
Formulation
PBS with 0.02% sodium azide and 50% glycerol pH 7.3.
-
Storage instructions
Store at -20℃. DO NOT ALIQUOT
-
Applications
Recommended Dilution:
WB: 1:1000-1:10000
IHC: 1:20-1:200
IF: 1:20-1:200
-
Validations

Jurkat cells were subjected to SDS PAGE followed by western blot with Catalog No:108415(BAK antibody) at dilution of 1:3000

Immunohistochemistry of paraffin-embedded human tonsillitis tissue slide using Catalog No:108415(BAK Antibody) at dilution of 1:200 (under 10x lens).
Immunohistochemistry of paraffin-embedded human tonsillitis tissue slide using Catalog No:108415(BAK Antibody) at dilution of 1:200 (under 40x lens).

Immunofluorescent analysis of HeLa cells using Catalog No:108415(BAK Antibody) at dilution of 1:50 and Alexa Fluor 488-congugated AffiniPure Goat Anti-Rabbit IgG(H+L)
-
Background
BAK1, also named as BAK, BCL2L7 and CDN1, belongs to the Bcl-2 family. In the presence of an appropriate stimulus, BAK1 accelerates programmed cell death by binding to, and antagonizing the anti-apoptotic action of BCL2 or its adenovirus homolog E1B 19k protein. Low micromolar levels of zinc ions inhibit the promotion of apoptosis. (PMID:17157251) BAK1 gene product primarily enhances apoptotic cell death following an appropriate stimulus. It can inhibit cell death in an Epstein-Barr virus-transformed cell line.
-
References
- Chen W, Hou J, Yin Y. alpha-Bisabolol induces dose- and time-dependent apoptosis in HepG2 cells via a Fas- and mitochondrial-related pathway, involves p53 and NFkappaB. Biochemical pharmacology. 80(2):247-54. 2010.
- Yin Y, Chen W, Tang C. NF-κB, JNK and p53 pathways are involved in tubeimoside-1-induced apoptosis in HepG2 cells with oxidative stress and G₂/M cell cycle arrest. Food and chemical toxicology : an international journal published for the British Industrial Biological Research Association. 49(12):3046-54. 2011.
- Hu M, Xu L, Yin L. Cytotoxicity of dioscin in human gastric carcinoma cells through death receptor and mitochondrial pathways. Journal of applied toxicology : JAT. 33(8):712-22. 2013.
- Lei JC, Yu JQ, Yin Y, Liu YW, Zou GL. Alantolactone induces activation of apoptosis in human hepatoma cells. Food and chemical toxicology : an international journal published for the British Industrial Biological Research Association. 50(9):3313-9. 2012.
- Jia Y, Ji L, Zhang S. Total flavonoids from Rosa Laevigata Michx fruit attenuates hydrogen peroxide induced injury in human umbilical vein endothelial cells. Food and chemical toxicology : an international journal published for the British Industrial Biological Research Association. 50(9):3133-41. 2012.
- Zhao X, Cong X, Zheng L, Xu L, Yin L, Peng J. Dioscin, a natural steroid saponin, shows remarkable protective effect against acetaminophen-induced liver damage in vitro and in vivo. Toxicology letters. 214(1):69-80. 2012.
- Zhang S, Lu B, Han X. Protection of the flavonoid fraction from Rosa laevigata Michx fruit against carbon tetrachloride-induced acute liver injury in mice. Food and chemical toxicology : an international journal published for the British Industrial Biological Research Association. 55:60-9. 2013.
- Wang H, Dong D, Tang S, Chen X, Gao Q. PPE38 of Mycobacterium marinum triggers the cross-talk of multiple pathways involved in the host response, as revealed by subcellular quantitative proteomics. Journal of proteome research. 12(5):2055-66. 2013.
Related Products / Services
Please note: All products are "FOR RESEARCH USE ONLY AND ARE NOT INTENDED FOR DIAGNOSTIC OR THERAPEUTIC USE"
